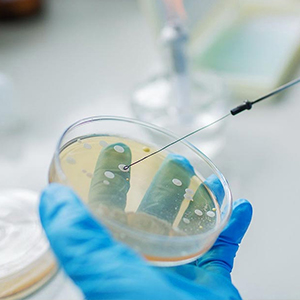
Санитарно-микробиологические исследования

Белыничский районный центр гигиены и эпидемиологии УЗ
Охрана здоровья населения посредством осуществления государственного надзора на территории Белыничского района.
-
+375 (2232) 7 79...arrow_drop_down
- +375 (2232) 7 79 09 (тел.)
Санитарно-микробиологические исследования
Белыничский районный центр гигиены и эпидемиологии УЗ
Гомельский областной центр гигиены, эпидемиологии и общественного здоровья ГУ
Государственный санитарный надзор Гомельской области. Санитарно-эпидемиологические услуги. Лабораторная диагностика, исследования, испытания. Комплексные обследования здоровья.. Консультации населения.
-
+375 (232) 50 74...arrow_drop_down
- +375 (232) 50 74 65 (Приемная)
- +375 (29) 366 27 25 (Тел.)
- +375 (232) 50 74 66 (Тел./Факс)
- +375 (232) 3 44 22 (Отдел по организации внебюджетной деятельности)
- +375 (29) 388 44 22 (Отдел по организации внебюджетной деятельности)
Житковичский районный центр гигиены и эпидемиологии ГУ
ЦГЭ. Осуществление государственного санитарного надзора.
-
+375 (2353) 5 46...arrow_drop_down
- +375 (2353) 5 46 72 (тел.)
Санитарно-микробиологические исследования
Житковичский районный центр гигиены и эпидемиологии ГУ
Институт биоорганической химии НАН Беларуси ГНУ
Научные исследования и научно-технические разработки в области химии, структуры и функции низкомолекулярных биорегуляторов и биополимеров.
-
+375 (17) 357 87...arrow_drop_down
- +375 (17) 357 87 61 (Приемная)
- +375 (17) 338 93 31 (Главный бухгалтер)
- +375 (17) 337 87 52 (Отдел кадров)
Минский областной центр гигиены, эпидемиологии и общественного здоровья Государственное учреждение
Государственная регистрация и государственная санитарно-гигиеническая экспертиза. Лабораторные радиологические исследования. Государственный санитарный надзор. Предотвращение заноса, возникновения и распространения инфекционных и массовых неинфекционных заболеваний.
-
+375 (17) 374 46...arrow_drop_down
- +375 (17) 374 46 85 (Приемная)
- +375 (17) 396 03 47 (Факс)
- +375 (17) 378 55 16 (Бухгалтерия)
- +375 (17) 342 61 74 (Юрист)
Санитарно-микробиологические исследования
Минский областной центр гигиены, эпидемиологии и общественного здоровья Государственное учреждение
Санитарно-микробиологические исследования
Минский областной центр гигиены, эпидемиологии и общественного здоровья Государственное учреждение
 в избранном
в избранном